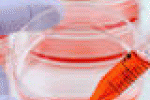
leggi tutto l'articolo Stop ai test sugli animali: quelli sulle colture cellulari sono ugualmente efficaci - greenMe.it Stop ai test sugli animali: quelli sulle colture cellulari sono ugualmente efficaci - greenMe.it

Notizie Sanità Medicina Salute da Google News

TGCOMDalle uova al latte, i dieci cibi commestibili anche dopo la data di scadenzaTGCOMLe indicazioni valgono per gli alimenti con etichetta "da consumarsi preferibilmente entro". Nella lista anche pane, patatine e cioccolato. Tweet. google. 0.... ...

TGCOMSalerno, 400 nuovi letti d'ospedale: inutilizzabili perché troppo larghiTGCOM15:08 - Quattrocento letti nuovi di zecca, ma inutilizzabili perché fuori misura: succede all'ospedale "Ruggi" di Salerno, che per l'acquisto, secondo la stampa... ...

La StampaLa caffeina non fa male al cuore, anzi lo proteggeAGI - Agenzia Giornalistica Italia(AGI) - New York, 27 gen. - La caffeina non provoca palpitazioni cardiache pericolose. A confutare quanti hanno timore che questa bevanda possa fare male... ...

Si24 - Il vostro sito quotidianoL'obesità riguarda 27 milioni di italiani Una pandemia da 100 mila nuovi casi l'annoSi24 - Il vostro sito quotidianoL'obesità è un fenomeno in aumento in Italia. Sono oltre 100 mila i nuovi obesi in Italia ogni anno... ...
greenMe.itStop ai test sugli animali: quelli sulle colture cellulari sono ugualmente efficacigreenMe.itPossiamo dirlo? Finalmente! Oggi è un giorno importante, tutte le maggiori agenzie di stampa e quotidiani riportano questa notizia: i test sugli... ...

Blasting NewsTest d'ingresso 2016, ecco le date di Medicina, Professioni Sanitarie e ArchitetturaBlasting NewsPer tutti gli studenti in procinto di iscriversi in una facoltà a numero chiuso l'attesa è finita: sono finalmente uscite le date dei test... ...